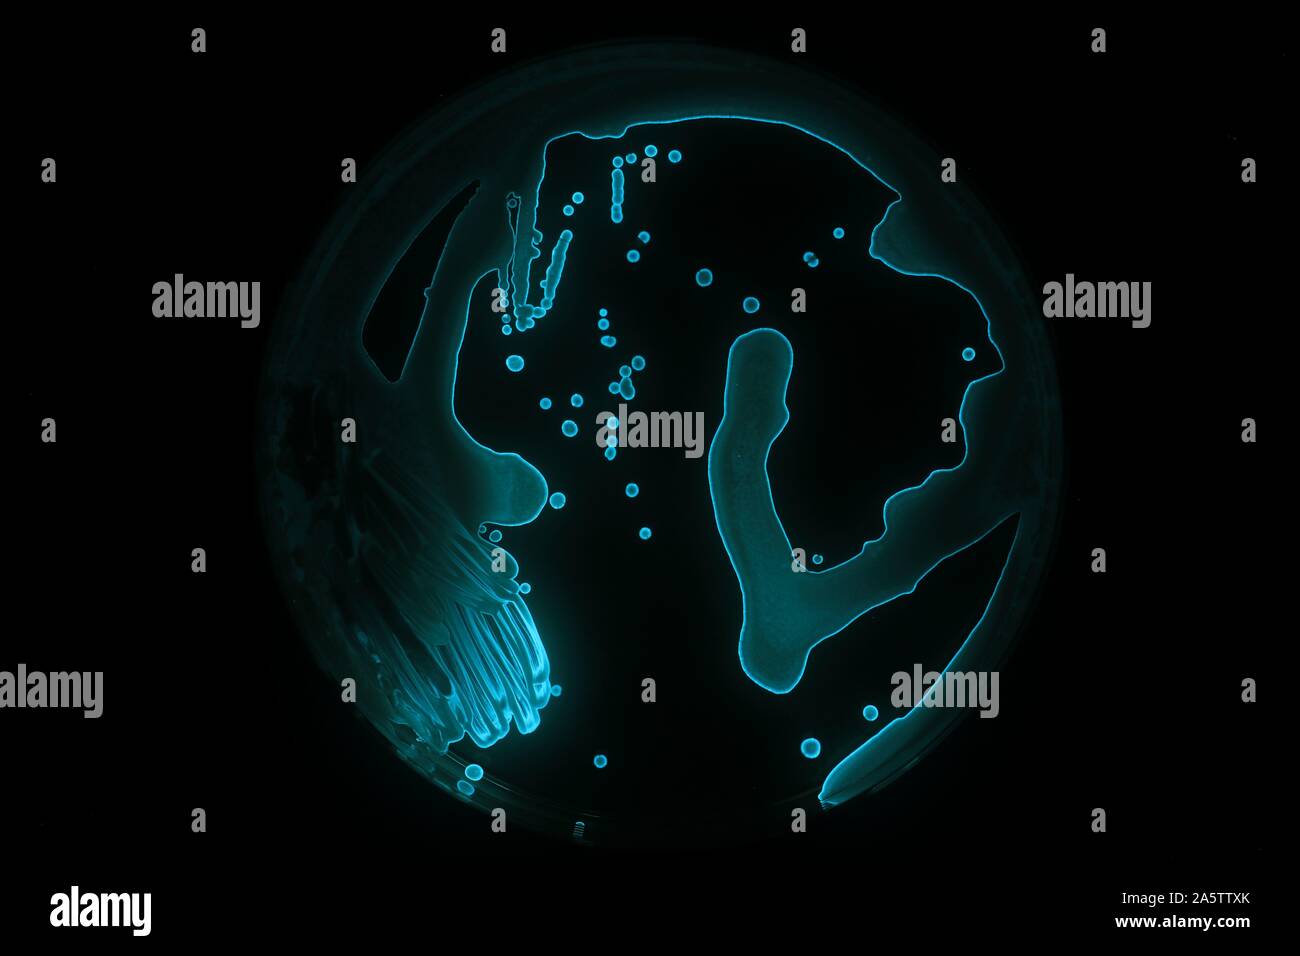
Aliivibrio hires stock photography and images Alamy
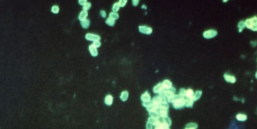
Better Know a Microbe Aliivibrio fischeri

Aliivibrio es un género de bacterias que incluye especies que anteriormente se clasificaban dentro del género Vibrio. Esta reclasificación fue posible gracias a un análisis de hibridación de ADN comparativo entre especies bacterianas pertenecientes al mismo género (Vidrio). Dichos estudios arrojaron que Vibratorio es un 70% diferente a Vidrio.[1] Son los bacilos responsables del efecto luminiscente que producen a veces las aguas de mar, efecto conocido como mar de ardora.
Actualmente, este género incluye únicamente seis especies:
- A. finisterrensis
- A. fischeri [2]
- A. logei
- A. salmonicida
- A. sifiae
- A. wodans
Etimología
El nombre Aliivibrio deriva de alius, que en latín significa “otro” y de Vibrio, nombre de un género bacteriano.
Características
Son bacilos gramnegativos bioluminiscentes [3] que se encuentran en todos los ambientes marinos, especialmente en mares templados y tropicales, por lo que cuentan con flagelos para desplazarse en su medio.[1]
Son anaerobios facultativos que poseen una capa gruesa de peptidoglicano, un componente necesario para el reconocimiento de un huésped simbólico.
Son heterotróficos, es decir, se alimentan de la materia orgánica presente en el agua. Sin embargo, también pueden ser bacterias saprofitas, y simbióticas, principalmente de moluscos y peces, alojándose en mucílagos o en microbio ta intestinal respectivamente.
Relaciones simbólicas
Los organismos marinos que contienen dichas bacterias usan la bioluminiscencia de estas para encontrar pareja, repeler a los depredadores, atraer presas o comunicarse con otros organismos. A cambio, el organismo huésped proporciona a la bacteria un ambiente rico en nutrientes.[4]
Metabolismo
Son quimioorganotróficos: su metabolismo depende de su estado actual en la columna de agua, ya sea de vida libre o simbiótica. Específicamente en simbiosis, la bacteria es capaz de metabolizar la glucosa y el monofosfato de adenosina cíclico (cAMP).
Cuando se cultivan en glucosa como medio de crecimiento, producen una gran cantidad de piruvato que puede ser utilizado por las células huésped para prevenir la acidificación del órgano en el que se encuentra la cepa.[5]
Luminiscencia
La luminiscencia en Aliivibrio está catalizada por la luciferasa bacteriana, que utiliza como sustratos O2 un aldehído alifático de cadena larga y un flavín mononucleótido reducido (FMNH2).
El sistema bacteriano luciferina-luciferasa está codificado por un conjunto de genes que forman el operón lux. De estos genes, algunos son activos en la emisión de luz visible y otros están involucrados en la regulación del operón. Varios factores conducen e inhiben la transcripción del conjunto de genes y, en consecuencia, producen o suprimen la emisión de luz.[6]
El operón lux es un fragmento del genoma que controla la bioluminiscencia mediante catálisis por la enzima luciferasa. Tiene una secuencia de genes conocida, que es LuxCDABE (F) E, donde Lux A y Lux B codifican componentes de luciferasa, y los genes Lux CDE codifican un complejo de ácidos grasos reducidos que produce los ácidos grasos para el mecanismo de luciferasa. El gen Lux C codifica la enzima acil-reductasa, la enzima Lux D acil-transferasa y Lux E, las proteínas necesarias para la síntesis de acil-proteína. La luciferasa produce luz azul/verde a través de la oxidación del mononucleótido flavina reducido (FMNH2) y el aldehído de cadena larga (R-CHO) por el oxígeno diatómico (O2).
El mononucleótido de flavina reducido (FMNH2) es proporcionado por un gen libre llamado LuxG.
Para generar el aldehído necesario en la reacción anterior, se unen tres enzimas adicionales. Los ácidos grasos requeridos para la reacción se obtienen en la ruta de biosíntesis de ácidos grasos por la acción de la enzima acil-transferasa. La acil-transferasa reacciona con acil-ACP para liberar un ácido graso libre (R-COOH). Este ácido graso se reduce mediante un sistema de dos enzimas a un aldehído:
Aunque el operón lux codifica las enzimas requeridas para que la bacteria brille, la bioluminiscencia está regulada por autoinducción. Un autoinductor es un promotor transcripcional de las enzimas requeridas para la bioluminiscencia. Antes de que pueda haber bioluminiscencia, debe estar presente una cierta concentración del autoinductor, el cual es dependiente de la densidad de población, por lo cual, la luminiscencia solamente se desarrolla cuando estas bacterias se encuentran en relaciones simbióticas con animales marinos, ya que la población es lo suficientemente densa como para que la luz producida sea visible para los animales. En contraposición, cuando las células de las bacterias luminosas se encuentran a baja densidad poblacional, como por ejemplo en el agua marina, el autoinductor se difunde y no se induce la luminiscencia.
Referencias